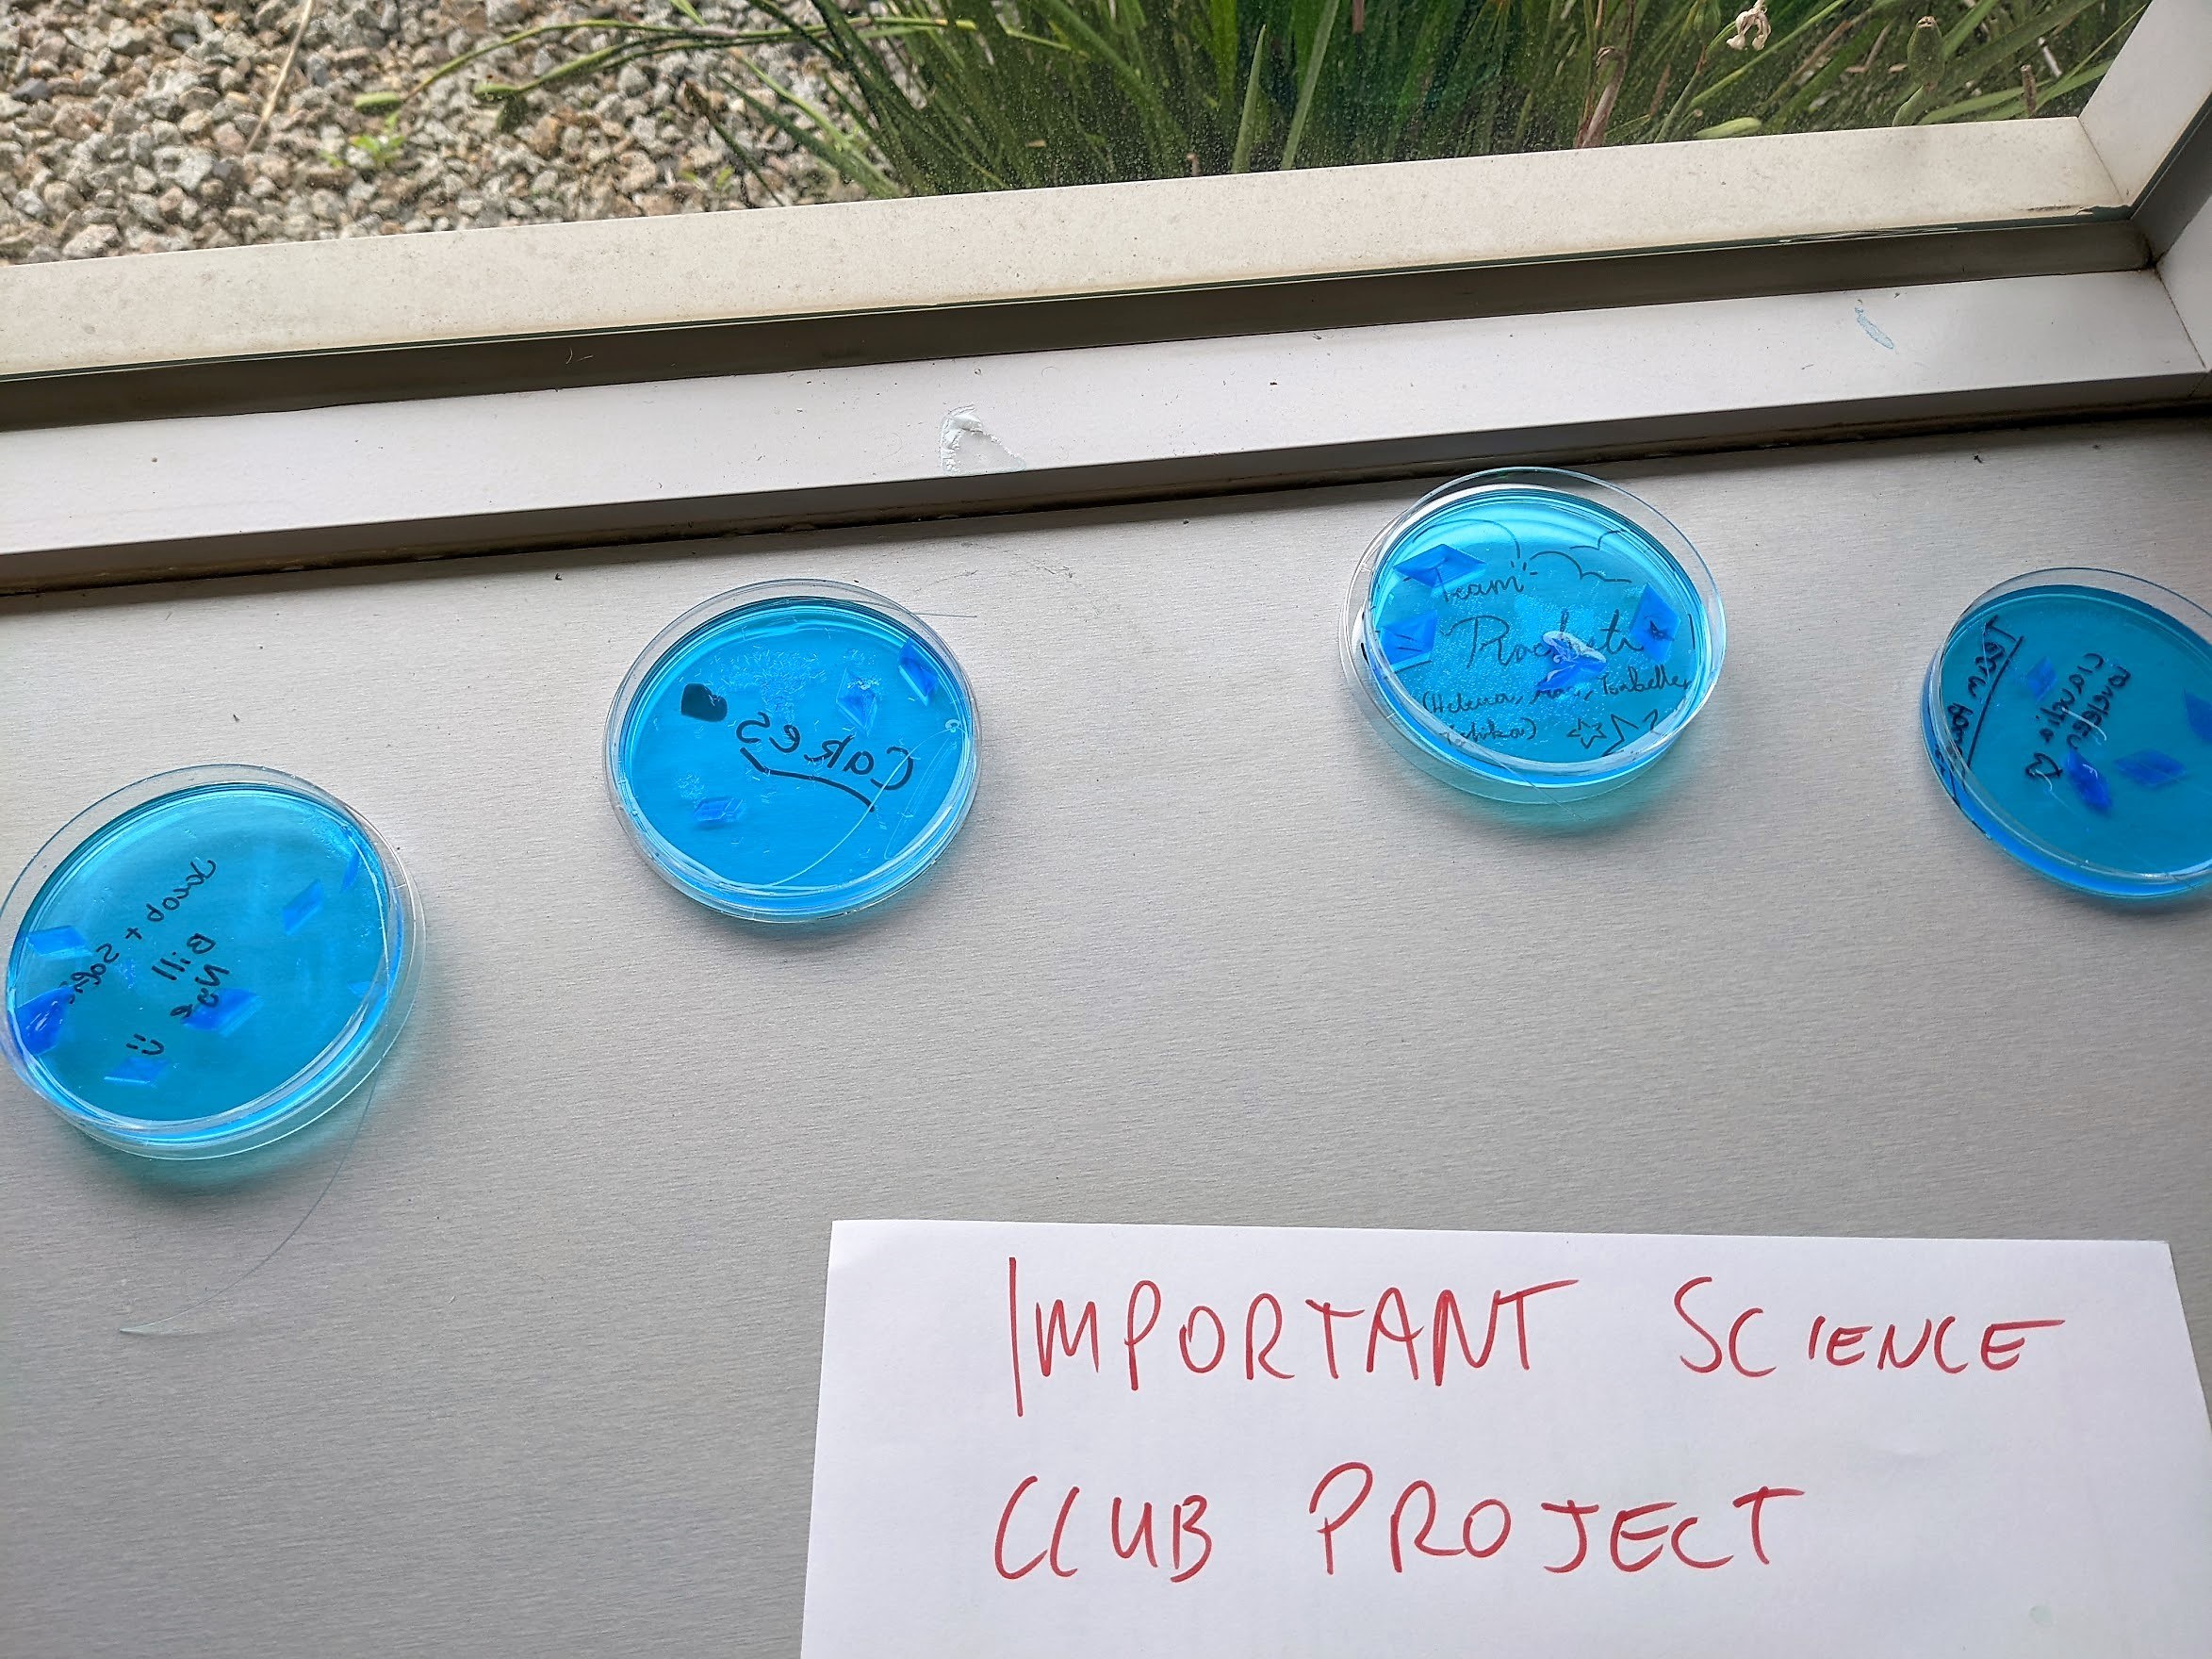

Science Club students embarked on a project to grow brilliant blue copper sulfate crystals
During Term One, students used their knowledge of Chemistry and mixtures to create a saturated copper sulfate solution. They used some of it to grow a seed crystal and then used their seed crystal to grow a larger crystal. The students observed their crystals underneath a light microscope and a 3D stereo microscope.
ALSO IN THIS SECTION
ALSO IN THIS SECTION